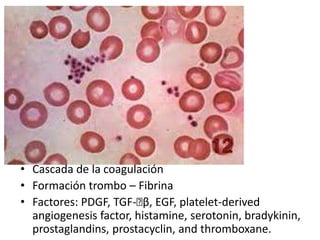
• Cascada de la coagulación
• Formación trombo – Fibrina
• Factores: PDGF, TGF-􏰁β, EGF, platelet-derived
angiogenesis factor, histamine, serotonin, bradykinin,
prostaglandins, prostacyclin, and thromboxane.
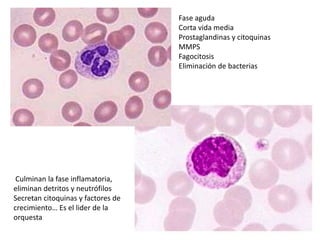
Fase aguda
Corta vida media
Prostaglandinas y citoquinas
MMPS
Fagocitosis
Eliminación de bacterias
Culminan la fase inflamatoria,
eliminan detritos y neutrófilos
Secretan citoquinas y factores de
crecimiento… Es el lider de la
orquesta
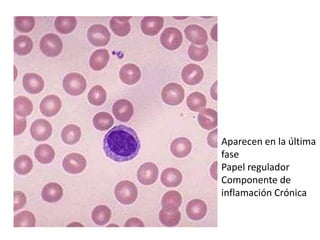
Aparecen en la última
fase
Papel regulador
Componente de
inflamación Crónica

La reparación tisular involucra regeneración y cicatrización. La regeneración permite la recuperación completa del tejido dañado mientras que la cicatrización puede producir alteraciones estructurales. El proceso de cicatrización involucra tres fases: hemostasia e inflamación, proliferación y remodelación. Células, matriz extracelular y señales moleculares juegan un papel clave en la reparación del tejido a través de estos procesos.